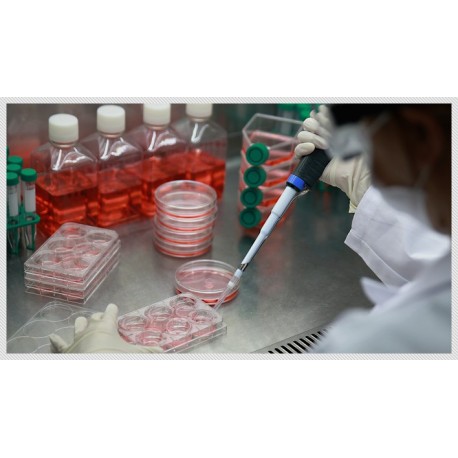
Linha de produtos SPL

Linha de produtos SPL
New
- Enviar a um amigo
- Remover dos meus favoritos
- Adicionar aos meus favoritos
More info
A SPL Lifesciences – Com experiência de mais de 20 anos no mercado de plásticos para laboratórios de Pesquisa Cientifica, a SPL traz extensa linha de produtos para trabalho com Cultura de Células, Ensaios Imunológicos, entre outros materiais. Seu amplo portfólio foi desenvolvido em colaboração com Cientistas, afim de garantir a qualidade e excelente performance dos produtos de sua marca
Produto |
Descricao |
Ref/Mod |
Marca |
UNID. |
004893 |
FRASCO DE CULTURA CELULAR, 25C |
70125 |
SPL |
PT |
005480 |
FRASCO ERLENMEYER PARA SUSPENS |
73000 |
SPL |
PC |
004896 |
FRASCO P/CULTURA CELULAR 650ML |
72175 |
SPL |
PT |
019878 |
FRASCO P/CULTURA CELULAR, 270M |
70175 |
SPL |
PT |
010941 |
MICROPLACA DE IMUNOLOGIA 96 PO |
32496 |
SPL |
PC |
005452 |
MICROPLACA P/IMUNO, ENSAIOS DE |
32384 |
SPL |
PC |
019815 |
PIPETA SOROLOGICA ESTERIL DESC |
91001 |
SPL |
PC |
019871 |
PIPETA SOROLOGICA ESTERIL DESC |
91002 |
SPL |
PC |
019865 |
PIPETA SOROLOGICA ESTERIL DESC |
91010 |
SPL |
PC |
004557 |
PLACA CULTURA CELULAR PETRI, 1 |
20151 |
SPL |
PC |
019817 |
PLACA CULTURA TECIDOS 24 POCOS |
30024 |
SPL |
PC |
019866 |
PLACA CULTURA TECIDOS 6 POCOS |
30006 |
SPL |
PC |
019855 |
PLACA CULTURA TECIDOS 96 POCOS |
30096 |
SPL |
PC |
019793 |
PLACA CULTURA TECIDOS 96 POCOS |
34096 |
SPL |
PC |
006278 |
PLACA DE CULTURA CONFOCAL (COM |
200350 |
SPL |
PC |
004454 |
RACK PARA 25 TUBOS DE CENTRIFU |
52015 |
SPL |
PC |
004378 |
RACK PARA 25 TUBOS DE CENTRIFU |
52050 |
SPL |
PC |
006489 |
STRAINER (PENEIRA) DE CELULAS, |
93040 |
SPL |
CX |
006284 |
STRAINER (PENEIRA) DE CELULAS, |
93070 |
SPL |
CX |
006287 |
STRAINER (PENEIRA) DE CELULAS, |
93100 |
SPL |
CX |
019846 |
TUBO CENTRIFUGACAO FUNDO CONIC |
50050 |
SPL |
PT |
019882 |
TUBO CRIOGENICO EM PP GRADUADO |
43012 |
SPL |
PT |